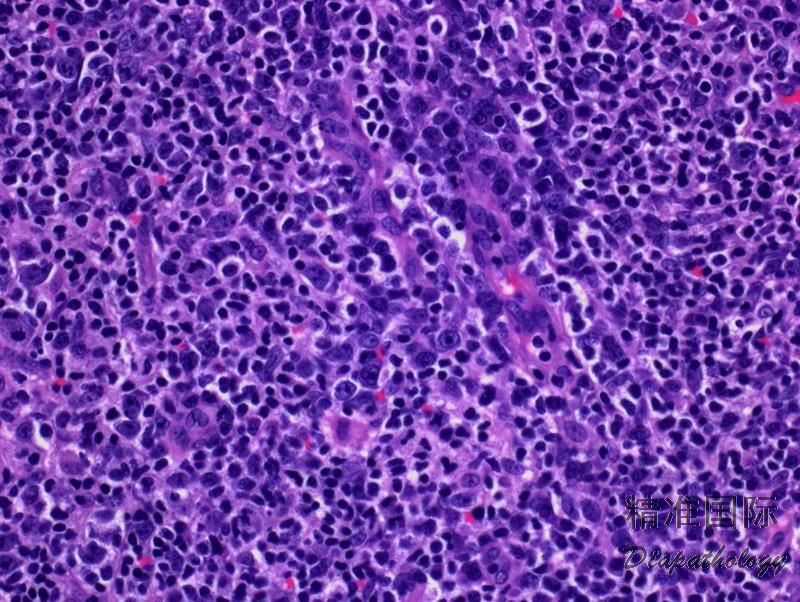

血管免疫母细胞性 T 细胞淋巴瘤
Angioimmunoblastic T Cell Lymphoma, AITL
同义词(或曾用名): 血管免疫母细胞性淋巴结病 ( AILD)
概述:
AITL 是一种外周 T 细胞淋巴瘤,来源于滤泡辅助性 T 细胞。其特征为系统性淋巴组织增生,多形性细胞侵润淋巴结并伴高内皮小静脉分支状增生和滤泡树突细胞广泛增生, 且几乎总是存在 EBV 阳性 B 细胞。临床表现为侵袭性,出现肝脾大、皮疹、贫血等全身症状和多克隆性高 γ 球蛋白血症。 WHO2017 年版将 AITL 归类为结性 T 细胞淋巴瘤伴滤泡辅助性 T 细胞表型,同一类的还有滤泡 T 细胞淋巴瘤及其它结性外周 T 细胞淋巴瘤伴滤泡辅助性 T 细胞表型。
发病部位: 淋巴结
诊断要点:
- 主要见于中老年,男性多见。全身淋巴结中大,肝脾大,皮疹,水肿伴体腔积液和全身 B 症状。血清学检查常有多克隆性高 γ 球蛋白血症、coombs 阳性溶血性贫血和自身免疫抗体。
- 淋巴结结构部分或完全破坏,多形性细胞弥漫侵润,常延至结外组织,但常不累及胞膜下窦。有时侵润位于残存滤泡周围或滤泡间。除异型淋巴细胞外,还有反应性细胞如嗜酸性粒细胞、浆细胞、组织细胞等。此外,背景中有大量、常呈分支状的毛细血管后高内皮静脉增生。
- 肿瘤淋巴细胞一般小到中等,也有散在大细胞。细胞核圆形或不规则,胞质透明,细胞膜清晰,常松散聚集成小灶状或融合成片。也可见散在免疫母细胞和偶尔 HRS 样细胞。
- 常有三种相互重叠生长模式:1)滤泡增生且结构基本完整,肿瘤细胞沿滤泡周围生长(其表达辅助 T 细胞抗原可与反应性滤泡增生鉴别);2)仍有残存滤泡,但萎缩变小,肿瘤细胞扩展到副皮质区;3)淋巴结结构完全或几乎完全破坏,残存滤泡或许偶见于显著增生扩张的副皮质区外周。
- 免疫表型:肿瘤细胞 CD3+、CD5+、βF1/TCR-αβ+、CD7+/-、CD4+,至少表达 2-3 个以上滤泡中心细胞抗原:Bcl6. CD10. PD1. CXCL13. ICOS、 SAP 和 CCR5,其中特异性较强的有 CXCL13 和 CD10,敏感性较高的有 PD1 和 ICOS。 CD21 和 CD23 显示滤泡树突细胞广泛增生,常围绕增生的高内皮静脉。有散在的 EBER+细胞(免疫母细胞样细胞,CD20+)。
- TCR 基因克隆性重排 (75-90%),IgH 基因克隆性重排(20-30%)。
- 细胞遗传学和基因突变:常突变的基因有 TET2. IDH2. DNMT3A、RHOA、CD28,融合的基因有 ITK-SYK 或 CTLA4-CD28,常见的染色体异常有 3+、5+、21+、+22q、+19. -13q-、6q 等。

免疫组织化学染色:
肿瘤细胞 CD3+、CD5+、βF1/TCR-αβ+、CD7+/-、CD4+,至少表达 2-3 个以下滤泡中心细胞抗原:Bcl6. CD10. PD1. CXCL13. ICOS、 SAP 和 CCR5,CD21 和 CD23 显示滤泡树突细胞广泛增生,常围绕增生的高内皮静脉。有散在的 EBER+细胞(免疫母细胞样细胞,CD20+)。
鉴别诊断:
滤泡 T 细胞淋巴瘤 (Follicular T-Cell Lymphoma):WHO2017 年版将 AITL 和滤泡 T 细胞淋巴瘤同归类为节性 T 细胞淋巴瘤伴滤泡辅助性 T 细胞表型。二者细胞学形态、免疫表型(至少表达 2-3 个滤泡中心细胞抗原)及分子生物学均相似或相同(如基因突变或融合,尽管发生频率可能不同),EBV 都可以阳性。所不同的是,滤泡 T 细胞淋巴瘤主要累及滤泡,呈现结节状增生,背景毛细血管后高内皮静脉增生不显著,通常也缺乏围绕其周围的滤泡树突细胞广泛增生,病变较局限,全身症状也较少见。
其它结性外周 T 细胞淋巴瘤伴滤泡辅助性 T 细胞表型 :淋巴结正常结构消失,肿瘤细胞呈现弥漫增生(混有炎性细胞和 B 细胞包括免疫母细胞或偶尔霍奇金样细胞),但背景毛细血管后高内皮静脉和滤泡树突细胞无明显增生,也无开启的包膜下窦。其细胞学形态、免疫表型(至少表达 2-3 个滤泡中心细胞抗原)及分子生物学均与 AITL 相似或相同(如基因突变或融合,尽管发生频率可能不同),EBV 也可以阳性。
外周 T 细胞淋巴瘤,非特指(PTCL,NOS):组织形态学包括增生的细胞成分与 AITL 相似,有时难以鉴别。支持 AITL 的证据包括开放的包膜下淋巴窦、CD21 染色显示出增生的滤泡树突细胞网、显著分支的内皮小静脉以及大多数病例 CD10+、Bcl6+、PD1+、EBER+。PTCL-NOS 则缺少上述这些特征。
T细胞/组织细胞丰富型大 B 细胞淋巴瘤(THRLBCL)或弥漫大 B 细胞淋巴瘤:AITL 中散在分布的免疫母细胞和炎性背景细胞,需与 THRLBCL 相鉴别。THRLBCL 中散在大细胞为具有明显异型性的肿瘤细胞,背景细胞为小淋巴细胞和组织细胞,无异型透明细胞,没有扩张的滤泡树突细胞网。有单克隆性 Ig 重链重排,无 TCR 基因克隆性重排。有的 AITL 病例有大量或成片 B 细胞增生,甚至合併弥漫大 B 细胞淋巴瘤。
混合细胞型经典霍奇金淋巴瘤 (MCCHL):AITL 中的 HRS 样细胞常 EBER+、CD20+、CD30+,加之背景炎性细胞,类似 MCCHL。但 MCCHL 背景无异型透明细胞,无滤泡树突细胞增生,血管增生也不明显,无 TCR 基因克隆性重排。临床表现和影像学也有助于鉴别。需注意的是,AITL 可以合併 CHL。
反应性副皮质区增生 :增生区可见小到中等大小淋巴细胞侵润,并伴有免疫母细胞和浆细胞,可类似早期 AITL。但淋巴结结构完整,无异型透明细胞,无滤泡树突细胞广泛增生。细胞混合表达 CD4 和 CD8,不表达 CD10 和 Bcl-6。TCR 基因重排阴性。
药物反应性淋巴增生 :常有全身淋巴结肿大,组织学表现为多形性细胞增生侵润和毛细血管后高内皮静脉增生,类似 AITL。但没有异性透明细胞,增生 T 细胞不表达 CD10 和 Bcl-6。EBER-。临床有用药史。
预后:
预后不良,中位生存期小于 3 年。
